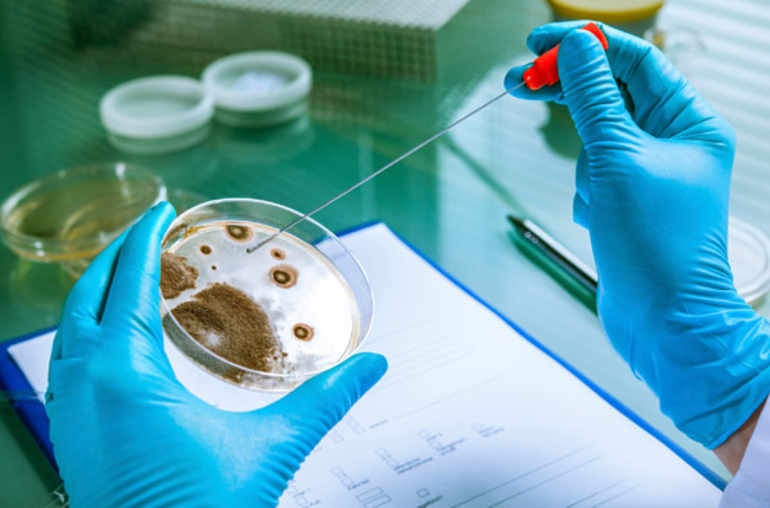

Hantavirus, qu’en est-il de la Suisse?
Une souris sylvestre de la Sierra Nevada est donc responsable de l’alerte sanitaire lancée dans le parc de Yosemite, en Californie. Le petit rongeur, porteur d’un virus hautement pathogène pour l’homme (hantavirus), s’est invité dans certaines tentes du parc national. A ce jour, huit personnes ont été infectées par le virus qui peut provoquer une forme de pneumonie, mortelle dans 40% des cas, trois d’entre elles sont décédées. Mais quelque douze mille personnes sont susceptibles d’avoir été en contact avec le virus entre le 10 juin et le 24 août; soit les campeurs qui ont dormi dans les tentes du Curry Village, et ceux qui ont choisi le campement de High Sierra Camps. L’épisode rappelle que les rongeurs peuvent être des vecteurs de maladies. Qu’en est-il des souris de nos contrées? Réponses de Laurent Kaiser, chef du laboratoire de virologie des Hôpitaux universitaires genevois.
Les souris européennes peuvent-elles aussi être porteuses d’un hantavirus?
Laurent Kaiser: Il existe trois grandes familles d’hantavirus. Celui que l’on trouve aux Etats-Unis a été découvert il y a 20 ans. Il s’appelle «Sin nombre» («Sans nom»), pour signifier que l’on n’arrivait pas à l’identifier lors de la première épidémie. Il peut provoquer une atteinte pulmonaire grave, le syndrome pulmonaire à hantavirus, mortel dans 40% des cas. Des cousins de ce virus circulent en Asie et dans les plaines de Russie, certains sont connus sous le nom de «Séoul». Ils se manifestent par de la fièvre, une pneumonie et des troubles de la coagulation. Il y a probablement des milliers de cas, y compris dans les mégapoles. En Europe enfin, on a affaire au «Puumala». La maladie est moins grave qu’aux Etats-Unis ou en Asie. Elle peut toucher les reins, mais n’a pas de répercussions vitales en général. On se trouve vraiment dans un cas exemplaire d’adaptation du virus à son milieu.
Et en Suisse, y a-t-il des cas de maladies à hantavirus?
C’est très rare. L’hantavirus Puumala circule en particulier dans l’Europe du Nord. Il touche des personnes particulièrement exposées aux rongeurs, comme les agriculteurs, les campeurs.
Si mon chat me rapporte des quantités de souris, y a-t-il un risque de transmission?
Cela suppose qu’une forte proportion de rongeurs soient infectés, ce qui n’est a priori pas le cas dans nos contrées. Et le contact avec des souris porteuses du virus ne signifie pas nécessairement transmission à l’homme. Il faudrait par exemple être exposé à un nuage de virus en suspension dans l’air. Comme le serait un fermier qui secouerait du foin contenant un nid de rongeurs contaminés. Au camping de Curry Village, la transmission a probablement pu se faire si des nids de souris se sont installés dans les tentes. Cela aurait favorisé la production d’aérosols respirés ensuite par les campeurs. Par contre, dans la nature, il faudrait beaucoup de malchance pour se contaminer. C’est un peu ce que l’on a observé avec la grippe aviaire. Les victimes, souvent des enfants, vivaient très proches des poules.
Les touristes de retour du parc de Yosemite affluent-ils aux urgences par crainte du syndrome pulmonaire à hantavirus?
Non, mais nos téléphones n’arrêtent pas de sonner. C’est fou le nombre de gens qui sont passés par ce parc! Nous devons les rassurer en étant très précis. Le risque d’attraper la maladie en parcourant le parc de Yosemite à pied est ainsi quasi nul. Les seules personnes concernées sont celles qui ont dormi dans les tentes infestées par les souris. Et même pour celles-ci, il n’est pas sûr qu’elles tombent malades.
A quoi faut-il prêter attention?
Aux circonstances dans lesquelles la personne se trouvait dans le parc. Au temps d’incubation, de trois à six semaines. Si un état grippal apparaît pendant ce laps de temps, et s’il se dégrade dans la semaine qui suit les premiers symptômes, avec notamment de la toux et des difficultés respiratoires, il faut consulter. Il n’y a pas de transmission connue de personne à personne à ce jour.
_________
|
|
Extrait de : Check-Up. Les réponses à vos questions santé |
|

Un centre pour les prochaines pandémies

Le point sur la variole du singe





